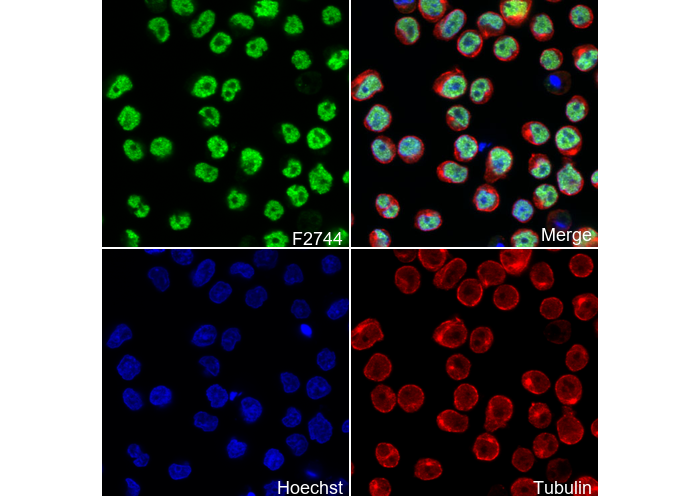

- 抑制剂
- 化合物库
- 热卖化合物库
- 定制您的化合物库
- 临床和上市相关
- 活性化合物总库
- 抑制剂相关
- 天然产物和药食同源相关
- 代谢相关
- 细胞死亡相关
- 按信号通路分类
- 按疾病分类
- 抗感染和抗病毒相关
- 神经和免疫相关
- 片段和共价相关
- FDA药物库
- 临床I期后及FDA药物库
- 临床前和临床药物库
- 已知活性药物库-I
- 生物活性库Ⅱ
- 激酶抑制剂库
- 多样性化合物母核库
- 天然产物库
- 人内源代谢化合物库
- 生物碱类化合物库New
- 血管生成相关化合物库
- 抗衰老化合物库
- 抗阿尔茨海默病化合物库
- 抗生素化合物库
- 抗肿瘤化合物库
- 抗癌化合物库-Ⅱ
- 抗癌代谢化合物库
- 抗心血管疾病化合物库
- 抗糖尿病化合物库
- 抗感染化合物库
- 抗氧化化合物库
- 抗寄生虫药物库
- 抗病毒化合物库
- 凋亡分子化合物库
- 自噬化合物库
- 钙通道阻滞剂库New
- Cambridge抗癌化合物库
- 糖代谢化合物库New
- 细胞周期化合物库
- 血脑屏障通透化合物库
- 共价抑制剂库
- 细胞因子抑制剂库New
- 细胞骨架信号通路化合物库
- DNA损伤/ DNA修复化合物库
- 类药性化合物库
- 内质网应激库
- 表观遗传化合物库
- 外泌体分泌相关化合物库New
- FDA抗癌药物库New
- 铁死亡化合物库
- 黄酮类化合物库
- 片段库
- 谷氨酰胺代谢化合物库
- 糖酵解化合物库
- GPCR小分子化合物库
- 肠道微生物代谢物库
- HIF-1信号通路化合物库
- 高选择性抑制剂库
- 组蛋白修饰化合物库
- 新药发现高通量筛选库
- 人类激素相关化合物库New
- 人转录因子化合物库New
- 免疫/炎症分子化合物库
- 抑制剂库
- 离子通道配体库
- JAK-STAT信号通路库
- 脂代谢化合物库New
- 大环化合物库
- MAPK抑制剂库
- 药食同源化合物库
- 代谢化合物库
- 甲基化化合物库
- 小鼠代谢化合物库New
- 天然有机化合物库
- 神经信号化合物库
- NF-κB信号通路库
- 核苷类似物库
- 肥胖化合物库
- 氧化应激化合物库New
- 植物提取物库
- 表型筛选库
- PI3K/Akt 抑制剂库
- 蛋白酶抑制剂库
- 蛋白-蛋白互作(PPI)抑制剂库
- 细胞焦亡化合物库
- 小分子免疫肿瘤化合物库
- 线粒体靶向化合物库New
- 干细胞分化化合物库New
- 干细胞小分子化合物库
- 天然酚类化合物库New
- 天然萜类化合物库New
- TGF-beta/Smad信号通路库
- 中药化合物库
- 酪氨酸激酶抑制剂分子库
- 泛素化化合物库
- 定制化合物库-1
- 定制化合物库-2
- 定制化合物库-3
- 定制化合物库-4
- 定制化合物库-5
- 定制化合物库-6
-
定制您的化合物库
通过在我们的库存中挑选化合物来建立合适的化合物库,用于您的研究工作。
请通过info@selleck.cn与我们联系,定制你所需要的化合物库。
您可以选择:
- 抗体
- 生物试剂
- qPCR
- 2x SYBR Green qPCR Master Mix
- 2x SYBR Green qPCR Master Mix(Low ROX)
- 2x SYBR Green qPCR Master Mix(High ROX)
- 蛋白实验
- Protein A/G免疫沉淀磁珠
- Anti-DYKDDDDK Tag免疫磁珠
- Anti-DYKDDDDK Tag亲和凝胶
- Anti-Myc免疫磁珠
- Anti-HA免疫磁珠
- 磁力架
- Poly DYKDDDDK Tag多肽
- 细胞核与细胞浆蛋白抽提试剂盒
- 免疫磁珠
- 蛋白酶抑制剂Cocktail
- 蛋白酶抑制剂Cocktail(DMSO储液)
- 磷酸酶抑制剂Cocktail
- 新产品
- 联系我们